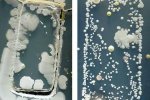
手機(jī)竟比馬桶還臟 細(xì)菌多

溫州在線 > TAG標(biāo)簽 >
細(xì)菌

濫用抗生素導(dǎo)致細(xì)菌產(chǎn)生耐藥性
2021年11月17日周三,泛美衛(wèi)生組織 (PAHO) 警告說,在新冠疫情期間過度使用抗生素和其他抗菌藥物正在幫助細(xì)菌產(chǎn)生耐藥性,隨著時間的推移,這些重要藥物將失效。

印度制造的噴霧劑中發(fā)現(xiàn)4種致病細(xì)菌
美國公共衛(wèi)生機(jī)構(gòu)表示,一種在印度制造并在美國銷售的芳香療法噴霧劑中發(fā)現(xiàn)4種致病細(xì)菌,今年早些時候?qū)е滤娜嘶疾。渲袃扇怂劳觥?/p>

隔夜冰西瓜一口吃下8400個細(xì)菌
隔夜冰西瓜一口吃下8400個細(xì)菌:每年都會有類似這樣“駭人聽聞”的實驗報告,細(xì)菌論個數(shù)還算什么呢?洗得再干凈的碗筷也有細(xì)菌。

保溫杯裝果汁爆炸 是細(xì)菌繁殖產(chǎn)生氣體
保溫杯裝果汁爆炸:西安城北的張女士把西瓜榨成汁放入保溫杯存入冰箱,竟然發(fā)生爆炸。這到底是什么原因呢?專家實驗證實,是果汁里大量細(xì)菌繁殖產(chǎn)生氣體造成爆炸。

被狗舔致四肢被切 感染病毒
美國一名男子被狗舔致四肢被切:據(jù)福克斯新聞網(wǎng)報道,美國威斯康辛州的48歲男子葛雷格(Greg Manteufel)被他自家寵物狗舔了以后感染病毒,還引發(fā)敗血癥,為了保命四肢被切。

被愛犬舔舐后截肢 英國醫(yī)生遭截肢毀容
被愛犬舔舐后截肢:媒體報道美國一名男子被愛犬舔舐后截肢,英國有一名醫(yī)生也是被狗舔了一下,感染犬咬二氧化碳嗜纖維菌,雙腿慘遭截肢毀容,失去了雙腿和6只手指和部分臉。

被愛犬舔舐后截肢 是截掉四肢啊
被愛犬舔舐后截肢:英國每日郵報報道,美國威斯康星州一名男子格雷戈·曼特費(fèi)爾被自己的愛犬舔舐后受細(xì)菌感染,結(jié)果四肢壞死,只得截去四肢,是截掉四肢啊。
手機(jī)竟比馬桶還臟 細(xì)菌多
手機(jī)竟比馬桶還臟:最近幾天朋友圈又在談這個話題,其實,早在大屏幕智能手機(jī)還沒流行的時候,就有媒體報道過相關(guān)新聞,除了手機(jī)外,鍵盤、水龍頭等等都被曝光過比馬桶臟。

7億人感染這細(xì)菌 幽門螺桿菌
7億人感染這細(xì)菌:微博熱傳中國有7億人感染這細(xì)菌,就是幽門螺桿菌。據(jù)世界衛(wèi)生組織的數(shù)據(jù),這種名叫幽門螺桿菌的細(xì)菌,與每年出現(xiàn)的新增胃癌病例,有著緊密的聯(lián)系。

妹子曬體檢報告 感染幽門螺桿菌數(shù)值爆表
妹子曬體檢報告:近日,云南昆明女白領(lǐng)劉小妹曬出單位組織體檢報告單,嚇傻了不少網(wǎng)友,感染幽門螺桿菌數(shù)值爆表數(shù)值高達(dá)678,正常數(shù)值50左右。





















